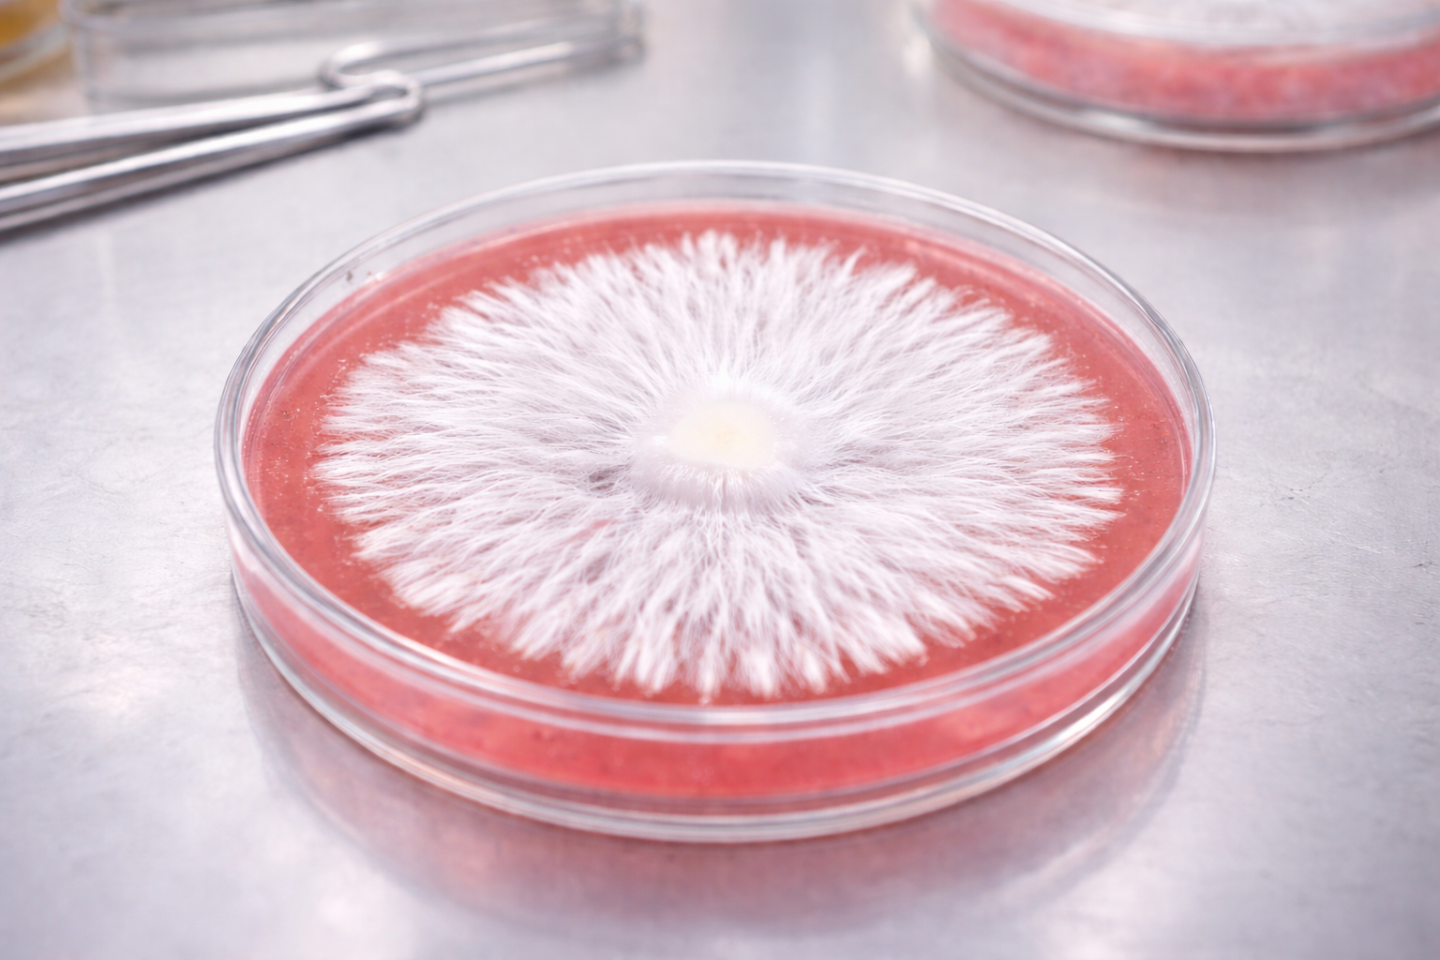

Mycology Lab is a private education community focused on applied mycology.
This community is for growers who want to move beyond trial-and-error and build consistent, repeatable cultivation systems using lab-based techniques.
Inside, members learn how to think in terms of process, environmental control, and workflow — not guesswork or shortcuts.
Topics include:
- Sterile technique and lab workflow
- Agar work and culture management
- Environmental control and system design
- Troubleshooting contamination and failures
- Scaling production with consistency
This is not a social feed or a beginner help group.
Mycology Lab is a working lab environment for serious growers who want reliable results.
Content is practical, systems-focused, and based on real-world cultivation experience.
powered by

skool.com/mycology-lab-8203
Applied mycology education for serious growers. Learn lab techniques, environmental control, and scalable systems for consistency.